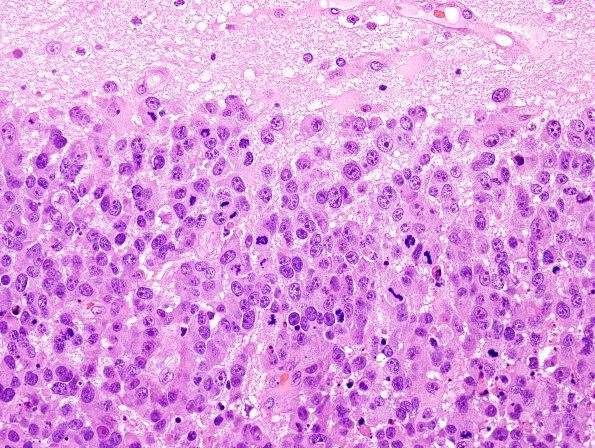
52B2 Metastasis, large cell neuroendocrine CA (Case 52) H&E 12.jpg

Table of Contents
Washington University Experience | NEOPLASMS (METASTASES) | Microscopic | 52B2 Metastasis, large cell neuroendocrine CA (Case 52) H&E 12.jpg
Sections of the "right frontal tumor" show sheets and nests of neoplastic cells with abundant cytoplasm with round, hyperchromatic nuclei containing prominent nucleoli, and numerous mitoses